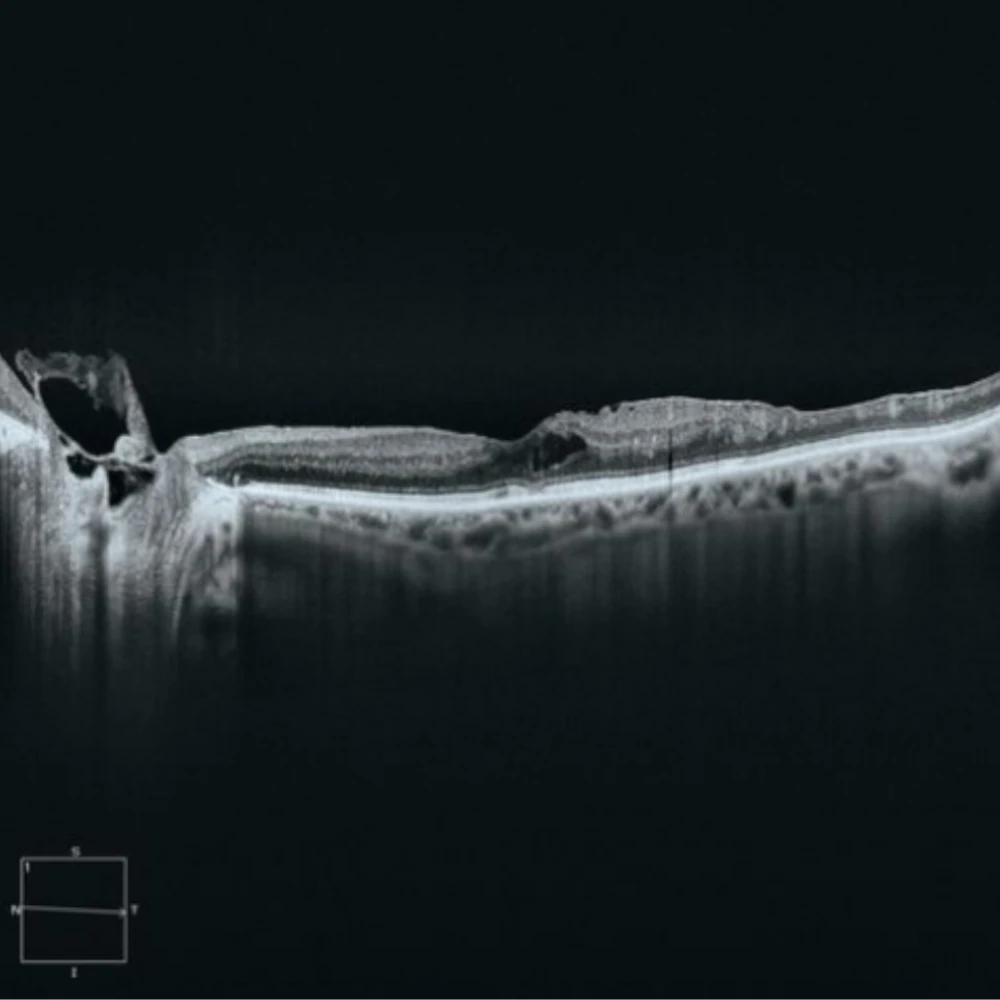
OCT CIRRUS 6000 3

OCT Cirrus 6000 – Zeiss
OCT de última generación con análisis de retina y segmento anterior, AngioPlex y reportes automáticos.
Ventajas principales:
✔ Alta resolución de 5 µm y escaneo rápido de 200 kHz
✔ AngioPlex OCTA integrado para vascularización
✔ Ergonomía y flujo optimizado de diagnóstico
✔ Conectividad DICOM y generación inmediata de informes
Descripción
El Cirrus 6000 de Zeiss representa la última generación de tomografía de coherencia óptica (OCT) de dominio espectral. Con tecnología avanzada y amplia capacidad analítica, permite diagnósticos detallados en retina y segmento anterior, optimizando el flujo clínico y la colaboración entre especialistas.
🛠️ Especificaciones técnicas:
-
Resolución axial: 5 µm
-
Escaneo de retina: 200 kHz, campo amplio de 12×9 mm
-
Retina profunda: profundidad de escaneo 2 mm
-
Segmento anterior: campo 15×6 mm (con módulo externo)
-
Funciones incluidas: AngioPlex OCTA, segmentation automática
-
Conectividad: DICOM, Wi‑Fi, grabación automática de informes
-
Ergonomía: pantalla táctil de 24″, joystick preciso
-
Dimensiones: compacto tipo torre, ruedas giratorias

Valoraciones
No hay valoraciones aún.